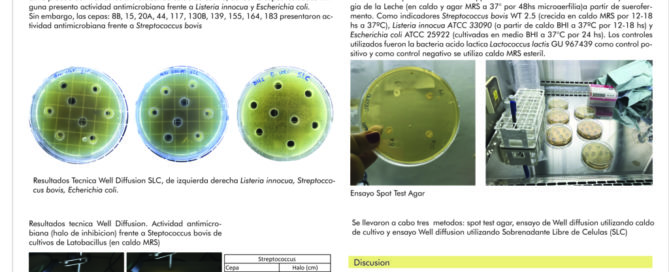

Avada includes a blog shortcode you can use anywhere on the site!
“Evaluación y selección de Lactobacillus spp con potencial bacteriocinogénico, aislados de suerofermentos naturales de queserías artesanales de la región Colonia-Uruguay”.
Se determinó la actividad antimicrobiana de cultivos de Lactobacillus provenientes de suerofermentos frente a tres microorganismos indicadores de interés tecnológico, como lo son Escherichia coli, Listeria innocua y Streptococcus bovis y en segundo lugar se [...]
FORMACIÓN Y CONOCIMIENTOS SOBRE SALUD Y ACTIVIDAD FÍSICA DE LOS INSTRUCTORES DE MUSCULACIÓN EN LOS GIMNASIOS DE LA CIUDAD DE RIVERA
El principal objetivo de esta investigación es dejar de manifiesto, el tipo de forma-ción que poseen los instructores de musculación de la ciudad de Rivera, así como los conocimientos y diferentes concepciones que éstos presentan [...]
Parasitosis intestinales en pacientes con Enfermedad Inflamatoria Intestinal de la Clínica de Gastroenterología del Hospital de Clínicas “Dr. Manuel Quintela”, un estudio caso-control, marzo-diciembre 2018.
Las parasitosis intestinales son infecciones del tubo digestivo causadas por protozoarios o helmintos. Su presencia se encuentra favorecida por condiciones socioeconómicas desfavorables e higiene deficiente. Existe un grupo de protozoos intestinales, antes considerados como comensales [...]